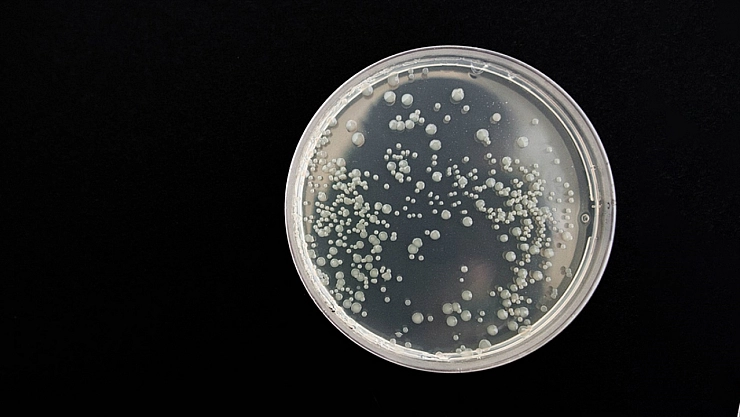
Bakteriler bakın en çok neden besleniyor?

Bakteriler bakın en çok neden besleniyor?
ABD merkezli yapılan bir araştırma, 'bakteriyel vampirizm' adı altında bazı ölümcül bakterilerin insan kanından beslendiği sonucuna ulaştı.
Washington Eyalet Üniversitesindeki (WSU) bilim insanları, kan dolaşımı enfeksiyonlarının oluşumunu incelerken bazı ölümcül bakterilerin insan kanındaki bir kimyasal maddeye yönelerek buradan beslendiğini ortaya koydu.
Araştırma lideri Siena Glenn, gıda kaynaklı salmonella, escherichia coli ve citrobacter koseri isimli 3 ölümcül bakterinin insan kanını hedef aldığına işaret ederek "bakteriyel vampirizm" özelliği gösteren tek hücreli bu mikroorganizmaların "vampir gibi" insan kanına eğilim gösterdiğini söyledi.
Bakterilerin özellikle bağırsak hastalığı olan kişilerde sindirim sistemindeki kesiklerden kan dolaşımına girebildiklerini kaydeden Glenn, bunların insan kanındaki maddeyi 1 dakika gibi kısa bir sürede tespit edebildiğini belirtti.
Glenn, bakterilerin kan kaynaklarına ulaşma şekillerini öğrendikten sonra buna uygun ilaç geliştirilebileceğini söyleyerek, bu ilaçlar sayesinde özellikle kan dolaşımı enfeksiyonu riski taşıyan insanların daha sağlıklı olabileceğini ifade etti.
İlgili araştırmanın sonuçları da "eLife" isimli bilim dergisinde yayımlandı.
Bakmadan Geçme